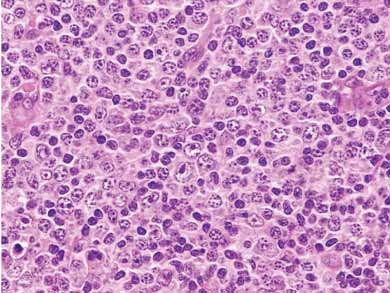

Konference: 2007 XIV. Jihočeské onkologické dny
Kategorie: Maligní lymfomy a leukémie
Téma: Diagnostika a léčba maligních lymfomů
Číslo abstraktu: 027
Autoři: Prof. MUDr. Alena Skálová, CSc.
- Lymfomy Waldayerova kruhu
Waldayerův kruh je tvořen lymfoidní tkání nasofaryngu, patrových tonsil, kořene jazyka a stěny orofaryngu. Tato oblast je druhým nejčastějším místem pro extranodální lymfomy po gastrointestinálním traktu (2). Pacienti jsou většinou starší 50 let a nejčastějšími příznaky jsou obstrukce dýchacích cest, bolest, porucha sluchu a ulcerace nebo tumor v oblasti Waldayerova kruhu. Patrové tonsily jsou postiženy nejčastěji. Lymfomy Waldayerova kruhu odpovídají většinou ne-hodgkinským lymfomům B-linie, a z nich je nejdůležitější difuzní velkobuněčný B- lymfom (DLBCL). DLBCL představuje až 80% lymfomů Waldayerova kruhu. Histologicky DLBCL sestává ze středně velkých a velkých polymorfních lymfoidních buněk B-řady (CD20+, CD79a+, CD19+) (obr. 1). Méně často infiltrují Waldayerův kruh jiné lymfomy, např. extranodální lymfom z marginálních buněk MALT typu, lymfom z buněk plášťové zóny, folikulární lymfom a periferní T-lymfom.
Obr.1. Difuzní velkobuněčný B- lymfom (DLBCL)
Hodgkinův lymfom infiltruje Waldayerův kruh velmi vzácně, nejčastějším typem je nodulární skleróza a typ s převahou lymfocytů. Diagnostické buňky Hodgkinova lymfomu mají charakteristickou histomorfologii a imunofenotyp (CD45-, CD15+ a CD30+). - Lymfomy horních cest dýchacích
Lymfoproliferativní léze v nosní sliznici a paranasálních sinusech jsou vzácné a představují méně než 5% extranodálních lymfomů. V minulosti, kdy byla klinická a diagnostická zkušenost s těmito lymfomy minimální, užíval se pro onemocnění nejčastěji název „letální granulom střední čáry“. Jde klinicky o agresivní a rychle rostoucí lymfom doprovázený bolestí, edémy, epistaxí a rozsáhlými ulceracemi ve sliznici. Moderní diagnostické metody umožnily tento velmi agresivní a lokálně destruktivní nádor klasifikovat jako lymfom z NK buněk (natural killer), a označuje se proto jako angiocentrický lymfom z NK/T buněk, nasální typ. Vyskytuje se u mladších jedinců a má patogenetický vztah k k EBV infekci (3). Další méně časté lymfomy v nosní sliznici jsou Burkittův lymfom, MALT-lymfom a extramedulární plasmocytom. - Lymfomy slinných žláz
Lymfomy slinných žláz představují pouze 3-5% všech nádorů slinných žláz. Parotis je nečastěji postiženou žlázou s 80% případů, následuje submandibulární žláza s 16 % případů. Lymfomy malých slinných žláz a sublinguální žlázy jsou extrémně vzácné (4). Pacienti s primárním lymfomem slinných žláz jsou v dospělém věku, častěji ženy. Asi 20% pacientů s lymfomem parotis má příznaky Sjogrenava syndromu. Nejčastějšími lymfomy parotis jsou extranodální lymfom z marginálních buněk MALT typu, folikulární lymfom a DLBCL. Lymfoepiteliální sialadenitis (LESA) příušní žlázy je prekurzorovou lézí pro MALT lymfom. LESA se histologicky skládá z lymfoidního infiltrátu a epimyoepiteliálních ostrůvků (benigní lymfoepiteliální léze) (obr. 2.). Původní struktura slinné žlázy je setřená atrofií a zánikem acinů a proliferací duktů do podoby epimyepiteliálních ostrůvků. S postupem času oligoklonální lymfoidní infiltráty kolem ostrůvků nabývají na objemu a vzniká neoplastický monoklonální infiltrát MALT lymfomu. Riziko vzniku lymfomu je v LESA až 50 krát vyšší než ve žláze bez LESA (5). Extranodální lymfom z marginálních buněk MALT typu je nízce maligní lymfom, který zůstává většinou lokalizovaný nebo infiltruje pouze regionální uzlinu. Ne úplně vzácně však může MALT lymfom v průběhu nemoci generalizovat a infiltrovat kostní dřeň. V MALT lymfomech různých orgánů byly detekovány rekurentní cytogenetické aberace, především translokace t(14:18)(q32:q21). V MALT lymfomech parotis se však genetické alterace vyskytují méně než v 10% případů.
Obr. 2: Extranodální lymfom marginální zóny MALT typu vznikající v lymfoepiteliální sialadenitidě

Folikulární lymfom je druhým nejčastějším primárním lymfomem slinných žláz (5). Morfologicky a imunofenotypem se neliší od příslušného lymfomu uzlinového (CD20+, bcl-2+), ale klinicky je většinou příznivější.
Difuzní velkobuněčný B-lymfom (DLBCL) vzniká ve slinných žlázách buď na podkladě MALT-lymfomu nebo de novo. V obou variantách jde o rychle rostoucí vysoce maligní lymfom s nepříznivou prognozou. - Extramedulární plasmocytom
Plasmocytomy jsou monoklonální nádorové proliferace plasmatických buněk. Přibližně 80% extramedulárních plasmocytomů vzniká v oblasti hlavy a krku. Pacienti jsou ve vyšším věku a muži jsou nápadně častěji postiženi než ženy. Nejčastějším místem je sliznice sinonasální (50%), dále Waldayerův kruh (30%), méně často další místa, jako larynx, farynx a ústní dutina. Histologicky je nádor tvořený polymorfními monoklonálními plasmocyty s restrikcí produkce lehkých řetízků imunoglobulinů. Prognoza je většinou příznivá, pouze u malé části pacientů dojde k rozsevu a přechodu v mnohotný myelom.
Literatura:
- Vega F, Lin P, Medeiros J: Extranodal lymphomas of the head and
neck. Ann Dign Pathol 2005: 9:340-350.
- Menarguez J, Mollejo M, Carrion R, et al: Waldayer’s ring
lymphomas. A clinicopathologic study of 79 cases. Histopathology
1994: 24:13-22.
- Mendenhall WM, Olivier KR, Lynch JW, et al: Lethal
midline-granuloma- nasal natural killer/T-cell lymphoma. Am J Clin
Oncol 2006: 29:202-206.
- Daniels T. Benign lymphoepithelial lesion and Sjogrens
syndrome. In: Ellis GL, Aucalir PL, Gnepp DR, ed. Surgical
pathology of the salivary glands. Major problems in pathology
series, vol 25, Philadelphia, WB
Saunders, 1991: pp 1-83. - Nakamura S, et al. Pathol Internat 2006:56:576-583.
- Hyjek E, Smith WJ, Isaacson PG. Primary B-cell lymphoma of salivary glands and its relationship to myoepithelial sialadenitis. Hum Pathol 1988:19:766-76.
Datum přednesení příspěvku: 13. 10. 2007
